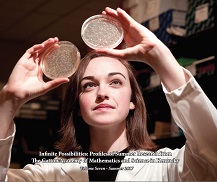
2017 book cover of female student biology researcher

The Gatton Academy's Research Internship Grant
The Gatton Research Internship Grant (RIG) program was created in 2010 through a gift from Mr. Carol Martin “Bill” Gatton. The RIG program offers grants to Gatton Academy students between their junior and senior years to support summer research internships at WKU, across the Commonwealth, the USA, and the world. By providing funding, the program directly creates research internships that otherwise would not have existed for Gatton Academy students. Past students have used their internships as a springboard to later apply for prestigious awards such as the Regeneron Science Talent Search and the Goldwater Scholarship. Many recipients submit their work for peer-reviewed publication and for conference presentations.

Deadline for submission will be Monday, March 9, 2026.
2026 RIG Application Form
Gatton Research Internship Grant Forms
2026 Student Evaluation Form and Grading Parameters
Regeneron Rules, Forms, and Resources
Regeneron Institutional Review Board (IRB) Approval Form
Learn more about the Gatton RIG Program
Gatton Research Internship Grant Past Recipients
Summer 2020 program was canceled due to COVID-19 pandemic.
Some of the links on this page may require additional software to view.